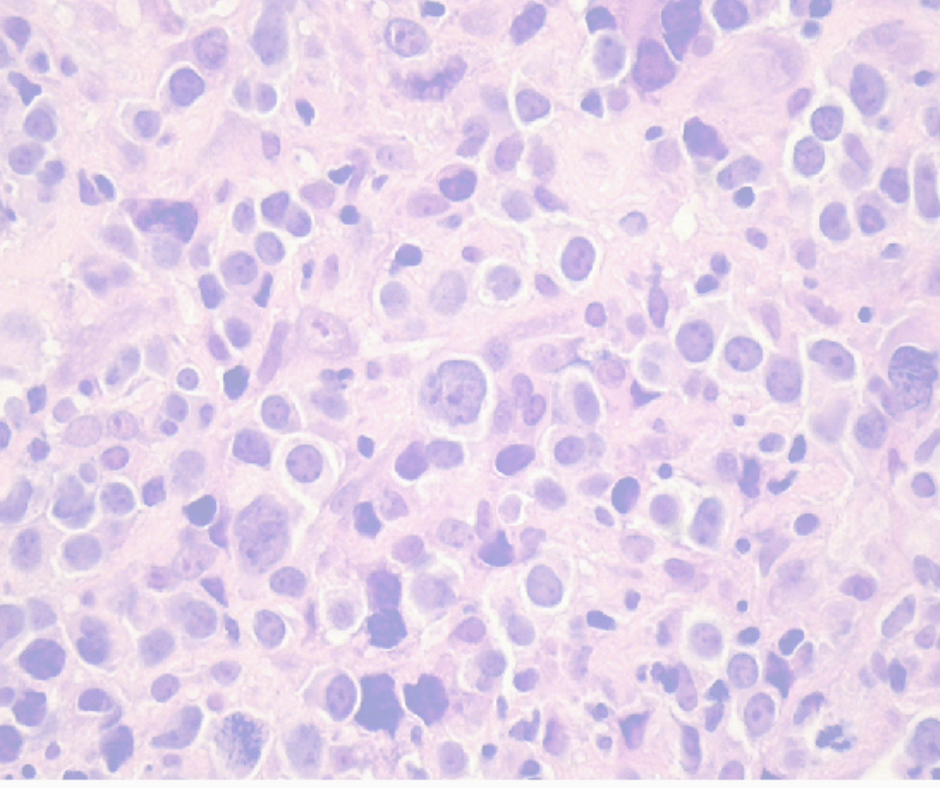

Une nouvelle publication axée DLBCL dans Blood Advances
Félicitations à l’équipe MOBIDIC à Rennes, Justine Ferrant, Mikael Roussel, Karin Tarte et à leurs partenaires pour leur publication dans Blood Advances : “Myeloid landscape profiling identifies DLBCL-specific suppressive macrophages colocalized with blood endothelial cells” 👏 Ce travail s’inscrit dans le cadre du projet collaboratif SpatialOmics, qui réunit plusieurs équipes du consortium CALYM autour d’un objectif […]
Position Paper : Disparités d’accès aux thérapies innovantes en Europe dans le LBCL

Publié le 23 septembre dans HemaSphere en complément des nouvelles guidelines européennes de l’EHA pour la prise en charge des LBCL, ce position paper est le fruit d’un travail collaboratif européen incluant des membres de l’Institut Carnot Calym : Florence Broussais-Guillaumot, Catherine Thieblemont, Hervé Tilly, de l’EHA et de la Lymphoma coallition. Cet article met en lumière : Le lymphome B […]